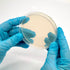

| Dimensions | 90 mm x 15 mm |
| Media | Potato Dextrose Agar |
| Autoclavable? | No |
These pre-poured sterile agar petri dishes are ideal for growing out fungal cultures, cloning wild mushroom specimens, and germinating fungal spores. Each dish contains pre-sterilized potato dextrose agar (PDA).
Pre-poured agar plates offer many benefits over pouring your own dishes. In addition to convenience, they are also less likely to contaminate your cultures because they are poured in a lab under an industrial-grade flow hood.
Storing unused plates:
For best results, use plates as soon as possible after receiving them. Store unused plates upright, at room temperature, and away from direct sunlight in the original packaging, preferably in a clean secondary container. (Unused plates can be stored upside down in the fridge. However, this can lead to condensation on the lid which can increase contamination risk.)
Check for condensation from time to time. Condensation in the plates means there is a heat source driving out water from the agar, which will dry out plates quickly. Before using, allow your plates equilibrate to room temperature.
Storing plates with cultures:
Once cultures are added to plates, store them right side up in the refrigerator.
You may also like
Making the world of mushrooms accessible to all
North Spore was launched in 2014 by a mycologist, an organic farmer, and a photojournalist -- three college friends brought together through their shared love of the mycological world.
What began as a simple love for mushroom foraging and cultivation quickly developed into an obsession with all things fungi. From there, an urban mushroom farm was born, as was the desire to spread the spore to the masses.
 i
i i
i i
i i
i i
i- Reviews
- Questions
Thank you for submitting a review!
Your input is very much appreciated. Share it with your friends so they can enjoy it too!
Perfect
I have had excellent results using these agar plates from North Spore. Great quality.
North Spore
Your plates look awesome, George! Thanks so much for sharing.
Sealed - Better than cheap Amazon Agar
Great product, low contam rate.
North Spore
We appreciate your business, Jake!
Agar for noms
These come sealed in a separate bag. Along with a still air box and good sterile techniques, they make cleaning up mycelium and isolating relatively easy. I recommend micropore tape or parafilm to make a band around it and help prevent contamination.
North Spore
We're happy to be part of your process, Hannah! Thanks for the review.
Agar all the way
I used to use spore syringes a lot to inoculate my bags and didn't it have the best of luck ever since I switched to agar plates I have been successful and growing my own mushrooms
North Spore
Great to hear, David! Our team is here to help if you ever need anything.
No contamination
All plates arrived contamination-free and have fostered quick growth. Excellent quality!
North Spore
Awesome, Dana! Thanks so much for sharing.














